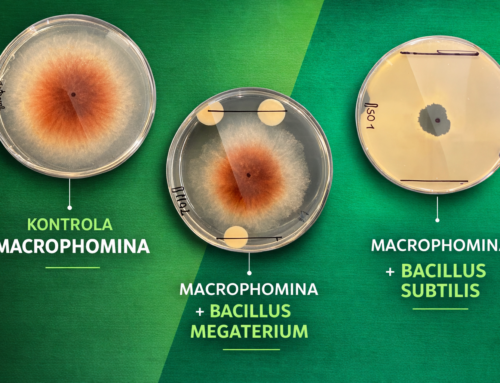
Wymierne korzyści dla rolników – Biologia gleby oparta na badaniach i danych

Grzyby strzępkowe patogeniczne infekujące z gleby (Fusarium, Aspergillus, Penicillium, Sclerotinia, Macrophomina) nie tylko negatywnie wpływają na plony, lecz także – poprzez produkcję mykotoksyn przez niektóre gatunki – zanieczyszczają jakość zbiorów, stanowiąc zagrożenie zarówno dla zdrowia ludzi, jak i zwierząt hodowlanych.
Od dawna wiadomo, że niektóre bakterie PGPR (promujące wzrost roślin) oprócz wspierania pobierania składników odżywczych i rozwoju roślin, są również zdolne do wypierania patogenicznych grzybów z ryzosfery – strefy korzeniowej roślin.
Myrazonit Rizo NG mikrobiologiczny preparat o szerokim spektrum działania:
nasz preparat Myrazonit Rizo NG spełnia wszystkie podstawowe wymagania stawiane nowoczesnym biostymulantom: łączy właściwości stymulujące wzrost roślin i mobilizujące składniki pokarmowe z silnym efektem biokontrolnym, ograniczającym rozwój i rozmnażanie się grzybów patogenicznych.
Jakie wyniki osiągnęliśmy dzięki zastosowaniu Myrazonit Rizo NG?
Między innymi:
-
5% wzrost plonów w kukurydzy – doświadczenia nadzorowane przez NÉBIH
-
8% wzrost plonów w papryce – doświadczenia NÉBIH
-
9% wzrost plonów w pomidorach – doświadczenia NÉBIH
-
11% wzrost plonów w pszenicy – doświadczenia w Martonvásár
-
18% wzrost plonów w uprawie wielkotowarowej słonecznika
-
37% spadek liczby kolb kukurydzy porażonych przez fuzariozę
-
38% redukcja zawartości toksyny fumonizynowej w kukurydzy
Zalecamy stosowanie preparatu we wszystkich uprawach polowych i ogrodniczych, jednak w systemach monokulturowych i dwupolowych, a także na stanowiskach porażonych przez Fusarium i Sclerotinia, jego użycie jest szczególnie rekomendowane.